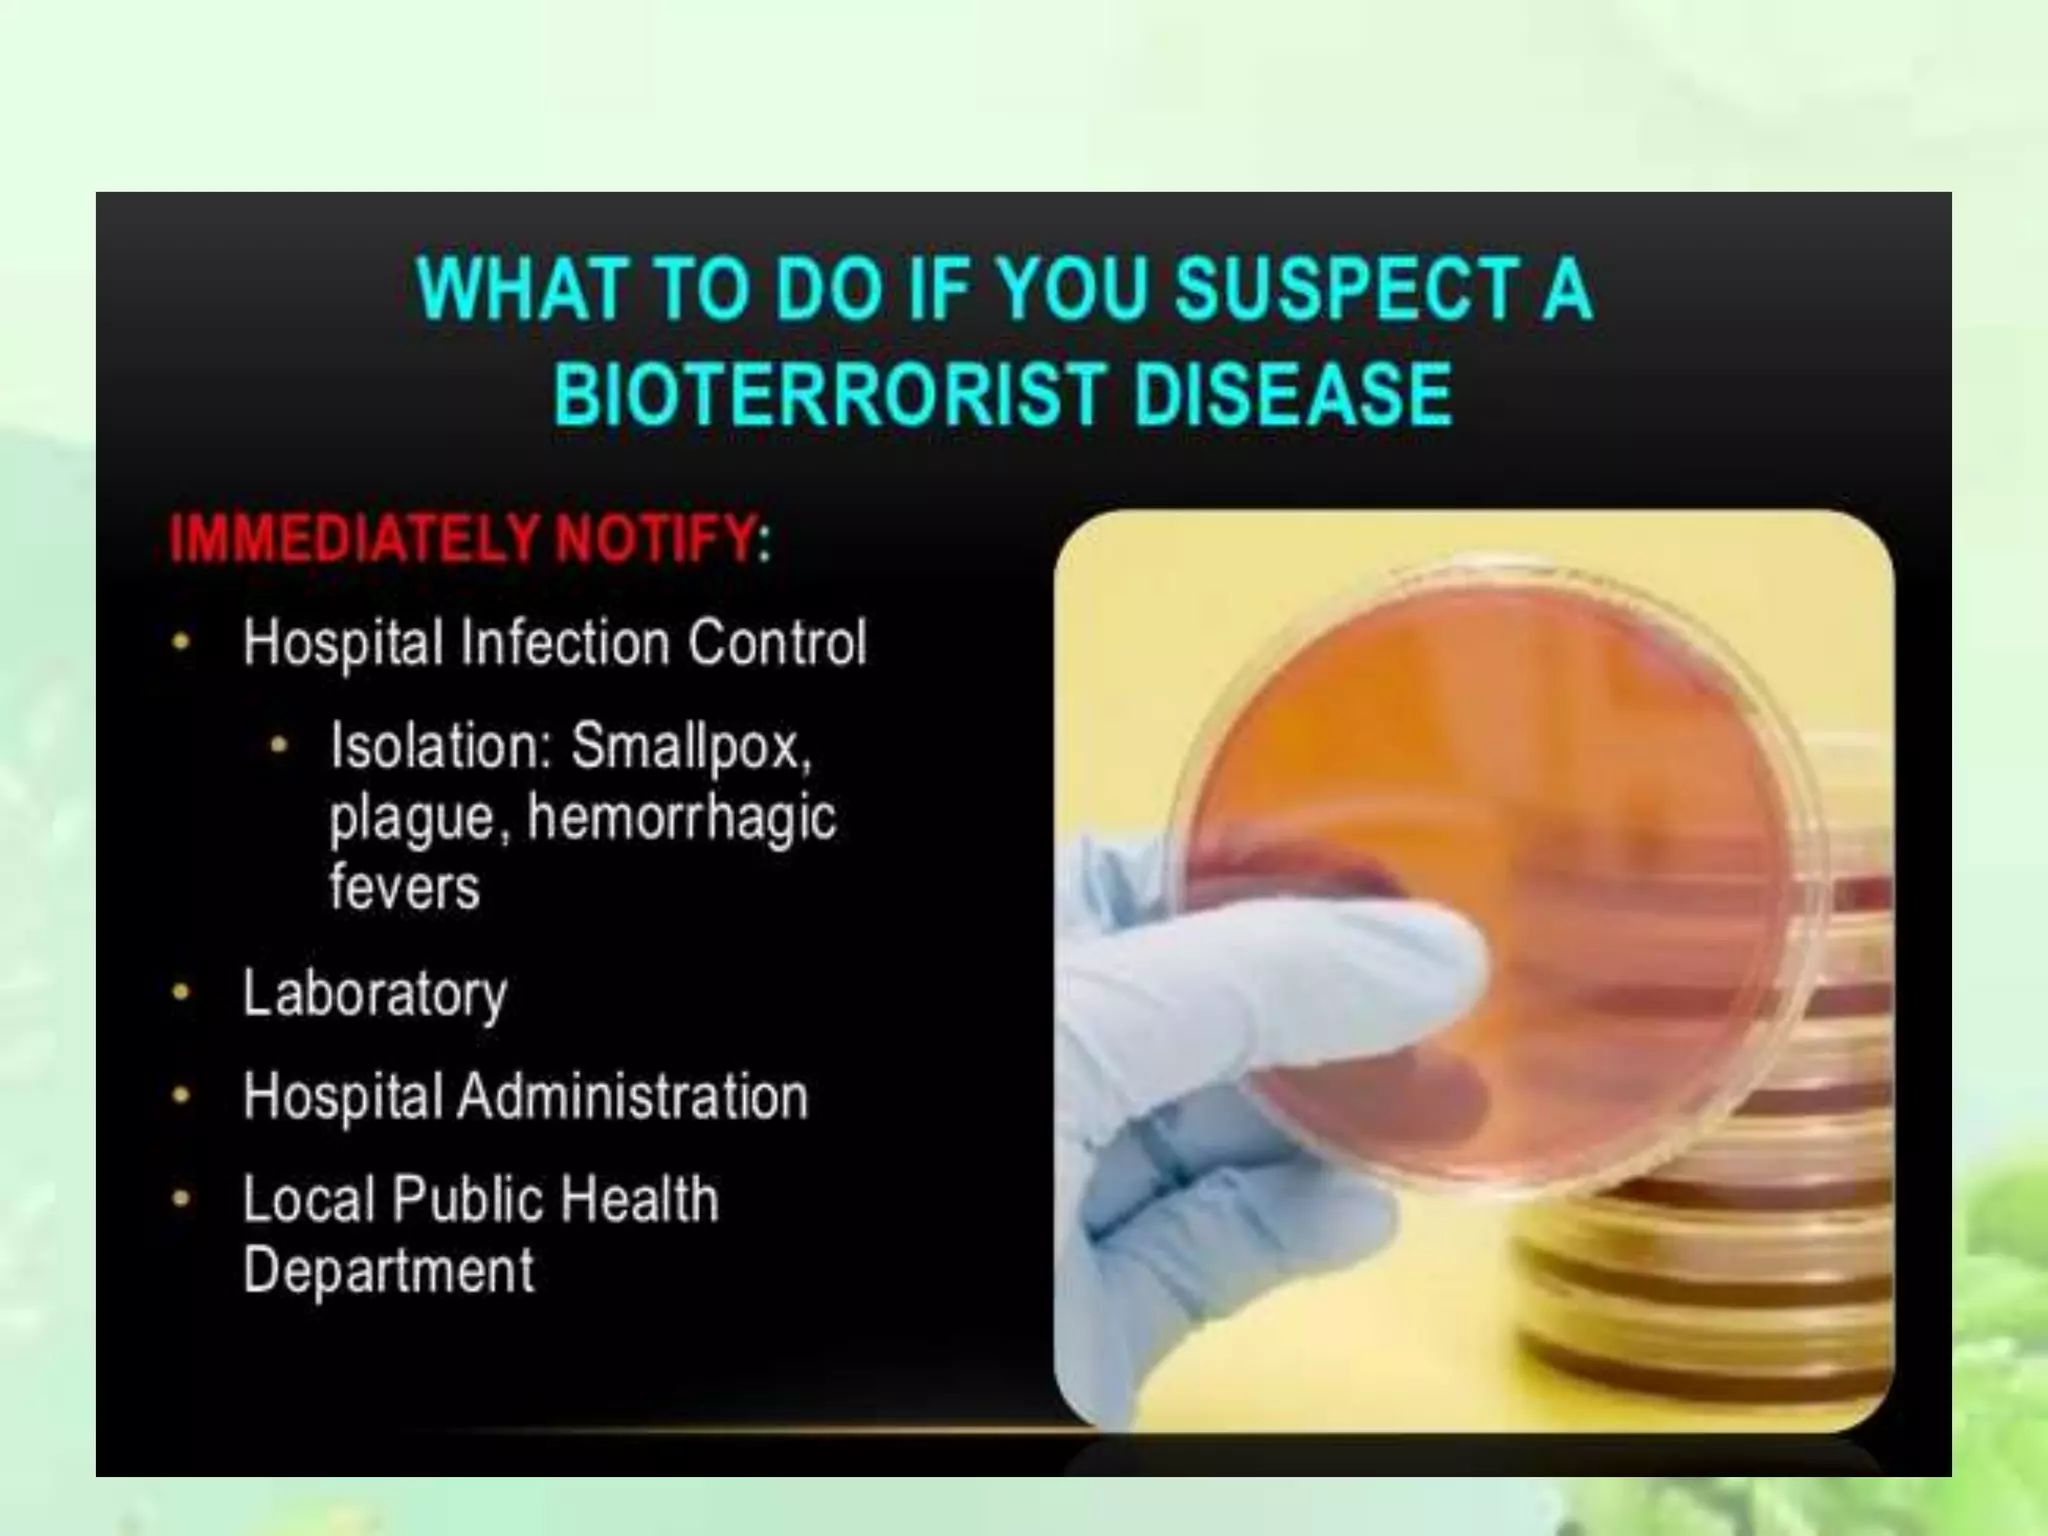

The document discusses bioterrorism, defining it as the deliberate release of harmful biological agents to cause illness or death. It outlines the characteristics of biological agents used, historical attempts at biological warfare, and classifications of bioweapons such as CDC categories A, B, and C. Additionally, it emphasizes the need for preparedness against potential bioterrorism attacks through familiarization, disaster planning, and advanced detection systems.